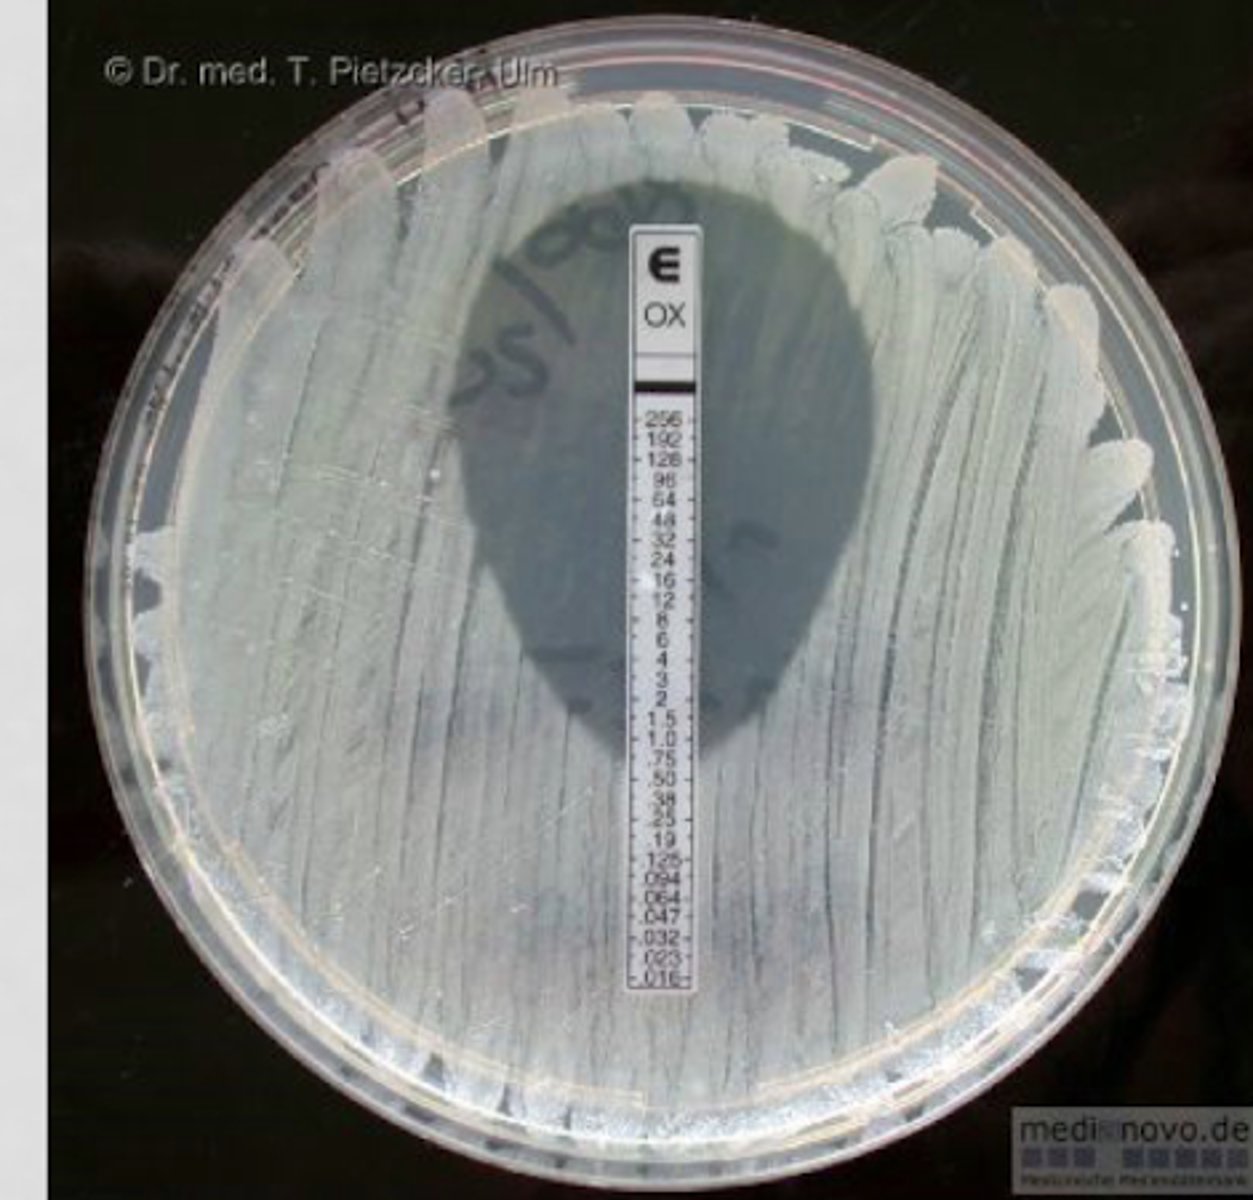
<p>utilizes a plastic strip with a pre-defined, stable gradient of antibiotic concentrations to produce a precise, drop-shaped inhibition ellipse on an inoculated agar plate</p>

1/62
Looks like no tags are added yet.
Name | Mastery | Learn | Test | Matching | Spaced | Call with Kai |
|---|
No analytics yet
Send a link to your students to track their progress
Antibiotic course

Convential identification
- phenotypic methods
- positive blood culture -> gram stain -> biochemical tests
Rapid diagnostic identification
positive blood culture -> gram stain -> rapid diagnostic test
Goals
- identify organism
- determine antimicrobial susceptibility
- selection of appropriate antimicrobial regimen
different between conventional and rapid diagnostics
- Time
- conventional can take 2-3 days
- rapid within hours
Quicker identification leads to
- more timely antimicrobial optimization
- decrease mortality
- shortened hospital stay
- lower hospitalization costs
Conventional microorganism identification
- media inoculation & microbial growth monitoring
- gram stain
- subculture colonies to agar (identification and susceptibility testing)
When is empiric therapy used with conventional?
- up to first 72 hours
- blood culture collection
- gram stain alert
- microorganism ID
When does definitive therapy begin with conventional?
after susceptibilities are found
What is an MIC?
- Minimum inhibitory concentration
- shortens time to get actionable data
- allows for quantitative determination of in vitro antibacterial activity
MIC is the pharmacodynamic parameter most often used
to characterize antimicrobial activity (AUC/MIC)
How long does MIC take?
18-24 hours
MIC methodologies
- broth microdilution is the gold standard reference but not practical
- broth macrodilution
- agar dilution
- relegated to reference or research lab due to time-consuming nature
Technologies for MIC
- VITEK 2
- Phoenix
Automated systems advantages
- reduces time to definitive culture results
- available for most commonly isolated organisms
Automated systems disadvantages
- not for all pathogens/antibiotics (especially newer antibiotics)
- not all MICs can be tested
E-testing
utilizes a plastic strip with a pre-defined, stable gradient of antibiotic concentrations to produce a precise, drop-shaped inhibition ellipse on an inoculated agar plate
E-testing is available for
- newer drugs and expanded MIC ranges
- Eravacycline
- imipenem/ cilastatin/ relebactam
If considering eravacyclin or imipenem/cilastatin/ relebactam
ask for ETEST on front end (eg known MDR pathogen)
When should you get culture?
before giving antibiotics because they decrease yield of culture if given prior (unless in emergency)
What infections require fast admin of ABX?
- severe
- meningitis (45 min)
- sepsis (1 hour)
Issue with breakpoints
FDA and CLSI don't always agree
Who gets the final call on breakpoints?
FDA since they are the ones who make the automated testing cards for machines
Benefits of rapid diagnostics
- much faster
- easy detection of resistance mechanism
- sensitive (true positive rate)
- specific (true negative rate)
Current rapid diagnostic tests
- Polymerase chain reaction (PCR)
- Multiplex PCR
- Nanoparticle probe technology
- matrix-assisted laser desorption/ ionization time-of-flight mass spectrometry (MALDI-TOF MS)
- multiplex FISH
- peptide nucleic acid fluorescent in situ hybridization
PCR
C diff
Multiplex PCR
- blood, sputum, meninges, GI
- 1 hour
Nanoparticle probe technology
- blood
- 2.5 hours
Multiplex FISH
- accelerate
- gives antimicrobial susceptibilities in 7 hours
New microbiology timeline

PCR
- amplification of a target piece of DNA + organism detection
- fluorescently labeled probe and 1 set of primers
PCR steps
- nucleotide extraction
- PCR amplification
- pathogen detection
BD's Geneohm's Cdiff assay
- rapid detection of toxigenic clostridium difficile
- highly sensitive and specific
BD's Geneohm's Cdiff assay results
B gene results in < 2 hours
BD's Geneohm's Cdiff assay importance
C diff increases LOS nearly x3 and mortality nearly x4.5
Multiplex PCR
- amplification of a target piece of DNA + organism detection
- fluorescently labeled probe and >1 set of primers
Filmarray Multiplex PCR System
- Blood culture identification (BCID) panel
- GI panel
- respiratory panel
- meningitis/encephalitis (ME) panel
- tests for common things
BCID panel results

GI panel
- tests for common GI pathogens
- 2 minutes hands on, turn around time of 1 hour
- 22 targets

Respiratory panel
- tests for common causes of upper respiratory tract infections
- sensitive and specific
- 2 minutes hands on, turn around time of 1 hour
- 20 targets
- Flu, COVID, RSV
Meningitis panel
- tests cerebrospinal fluid for the 14 most common pathogens related to community acquired meningitis or encephalitis
- 2 minutes hands on, turn around time of 1 hour
- 14 targets
ME panel results

Nanoparticle probe technology
nucleic acid extraction and PCR amplification
Nanoparticle probe technology steps
- nucleic acid extraction
- PCR amplification
- hybridization of target DNA
- signal amplification
Nanoparticle probe technology examples
- nanosphere verigene blood culture gram-positive (BC-GP) assay
- nanosphere verigene blood culture gram- negative (BC-GN) assay
Accelerate PhenoTest
- FISH
- Fluorescent In Situ Hybridization

Mass spectrometry
MALDI-TOF
MALDI-TOF
- mass spect
- determines elemental composition of a sample
MALDI-TOF mass spectrometry steps
- ionization fo molecules
- charged molecules measured based on mass-to-charge ratio
- generation of a "molecular signature"

MALDI-TOF mass spectrometry needs what first
growth
Rapid does not always mean
new technology. You should evaluate current process, check to see if you have culture results before rounds
Optimization can happen sooner with
process changes to report results "more rapid" (VITEK2)
Role of the antimicrobial stewardship pharmacist
- rapid diagnostics can dramatically reduce the time to pathogen identification
- positively impact patient care
Rapid diagnostics have dramatically reduced the time to pathogen identification
- discontinuation of antimicrobials
- de-escalation of antimicrobials
Most clinical pharmacists are familiar with what rapid diagnostic technology
PCR
What is the most commonly used rapid diagnostic test?
Multiplex PCR
Formal ID training was associated with
Higher rates of familiarity
Antimicrobial stewardship program ASP
- appropriate use of antimicrobial
- all pharmacists should be invested in antimicrobial stewardship in order to achieve goals
What is the goal of ASP?
- best patient outcomes
- decreased risk of adverse effects
- reduce levels of resistance
- decrease cost
Rapid diagnostic test can help achieve ASP goals by offering
- decreased time to microorganism identification
- easy identification of resistance mechanisms
Receiving results faster requires
someone acting on results (de escalation is seen in 1/2 the time)
conventional microorganism identification vs multiplex PCR + pharmacist-driven reporting
- reduced time to antibiotic change
- higher selection of optimal therapy
- reduced use of vancomycin for coagulase negative staphylococci contaminants
Conventional vs. rapid time
- conventional: 48-72 hours
- rapid: 2 or less hours